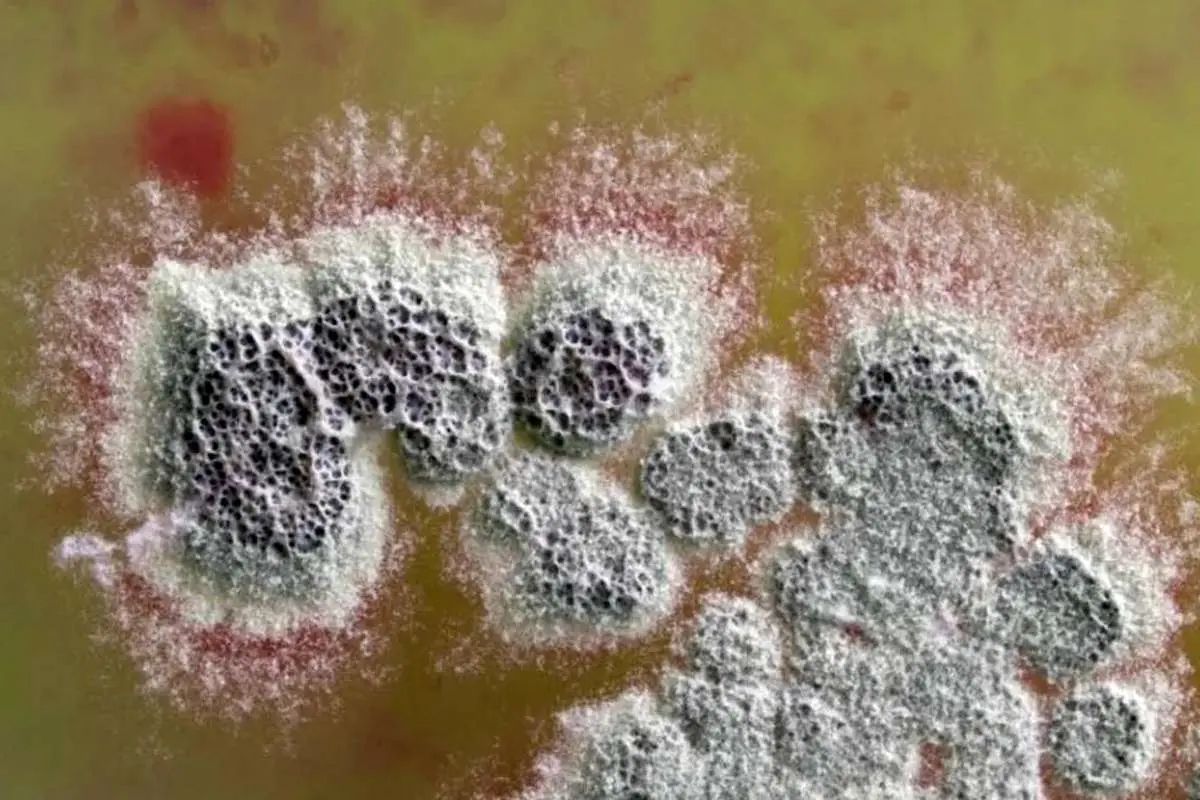
آنتی‌بیوتیک قدرتمندی که مقاوم‌ترین باکتری‌ها را نابود می‌کند

آنتیبیوتیک قدرتمندی که مقاومترین باکتریها را نابود میکند
مقاومت به آنتیبیوتیکها یکی از بزرگترین تهدیدات بهداشتی در جهان است و پیشبینی میشود طی ۲۵ سال آینده باعث مرگ ۳۹ میلیون نفر در سطح جهانی شود. یافته جدید میتواند به تولید داروهایی جدید برای مقابله با این بحران کمک کند.
پژوهشگران آنتیبیوتیک جدیدی کشف کردهاند که قدرت آن در برابر باکتریهای مقاوم به دارو بسیار بیشتر از آنتیبیوتیکهای موجود است.
به گزارش نیچر، به تازگی محققان آنتیبیوتیک جدید و قدرتمندی کشف کردهاند که قادر است باکتریهای مقاوم به دارو را از بین ببرد. این کشف میتواند راهحلی برای مقابله با یکی از تهدیدات بزرگ بهداشت جهانی، یعنی مقاومت آنتیبیوتیکی، باشد.
در پژوهش جدید، تیم تحقیقاتی به سرپرستی پروفسور گرگوری چالیس از دانشگاه وارویک انگلستان، فرآیند تولید داروی متیلنومایسین A توسط باکتری خاکی Streptomyces coelicolor را بررسی کردند. این دارو در سال ۱۹۶۵ برای نخستین بار شناسایی شد.
محققان در طول این پژوهش، ترکیب واسطهای به نام پرمتیلنومایسین C لاکتون را شناسایی کردند که فعالیت ضد میکروبی آن ۱۰۰ برابر قویتر از خود متیلنومایسین A است. حتی مقادیر اندک این ترکیب قادر به از بین بردن سویههای مقاوم به داروهای درمانی بوده که موجب عفونتهای سخت درمان میشوند.
پیدا شدن این ترکیب شگفتآور بود. پروفسور چالیس میگوید: «به طور معمول انتظار داریم تکامل محصول نهایی را به شکلی کامل و بهینه کند، بنابراین بهطور طبیعی باید انتظار داشته باشیم مولکول نهایی بهترین خاصیت آنتیبیوتیکی را داشته باشد، اما این کشف نشان داد که در این مورد، یک واسطه میتواند ویژگیهای برجستهتری نسبت به محصول نهایی داشته باشد.»
کلنی باکتری Streptomyces coelicolor ترکیب آنتیبیوتیکی (قرمز) را در محیط اطراف خود آزاد میکند.
مقاومت به آنتیبیوتیکها یکی از بزرگترین تهدیدات بهداشتی در جهان است و پیشبینی میشود طی ۲۵ سال آینده باعث مرگ ۳۹ میلیون نفر در سطح جهانی شود. یافته جدید میتواند به تولید داروهایی جدید برای مقابله با این بحران کمک کند.
پژوهش جدید نشاندهنده اهمیت تحقیقات بنیادی است که میتوانند به کشف ترکیبات شیمیایی جدید از مسیرهای تولیدی قدیمی کمک کنند. این تحقیقات نه تنها میتوانند درک ما از فرآیندهای شیمیایی را گسترش دهند، بلکه میتوانند به کشف داروها و ترکیبات بیواکتیو جدید نیز منجر شوند.
به گفته جرارد رایت، بیوشیمیست دانشگاه مکمستر کانادا، اینگونه مطالعات علمی به محققان این امکان را میدهند که از مسیرهای سنتزی که در گذشته شناخته شده بودهاند، ترکیبات جدید و مفیدی را شناسایی کنند که ممکن است در آینده کاربردهای گستردهای در درمان بیماریها داشته باشند.
در سال ۲۰۰۶، چالیس و همکارانش پژوهشهایی را برای بررسی مسیر مولکولی تولید متیلنومایسین A توسط باکتری S. coelicolor آغاز کردند. آنها به تدریج ژنهای مرتبط با تولید این دارو را حذف کرده و تحقیقاتی را انجام دادند که به شناسایی مولکولهای واسطهای منجر شد.
تا سال ۲۰۱۰، تیم تحقیقاتی فرآیند تولید متیلنومایسین A را شبیهسازی کرده و چندین ترکیب واسطهای را شناسایی کردند. در ابتدا این ترکیبها مورد توجه قرار نگرفتند، چرا که محققان نمیدانستند از آنها چه استفادهای کنند.
در سال ۲۰۱۷، یک دانشجوی دکترا در آزمایشگاه چالیس این ترکیبها را از نظر فعالیت ضد میکروبی مورد آزمایش قرار داد و متوجه شد یکی از این ترکیبات یعنی پرمتیلنومایسین C لاکتون، بسیار قویتر از متیلنومایسین A عمل میکند. این ترکیب حتی در مقادیر بسیار کم قادر به از بین بردن باکتریهایی مانند استافیلوکوک اورئوس و انتروکوک فاسیوم بود که موجب عفونتهای پیچیده و مقاوم به درمان میشوند.
تیم تحقیقاتی سپس آزمایشاتی انجام دادند تا ببینند آیا باکتریها میتوانند به این آنتیبیوتیک جدید مقاوم شوند یا نه. در آزمایشات طولانی مدت، باکتریهای انتروکوک فاسیوم که در معرض پرمتیلنومایسین C لاکتون قرار گرفته بودند، مقاومت ایجاد نکردند. درمقابل، در باکتریهایی که درمعرض وانکومایسین قرار گرفتند (آنتیبیوتیکی که در درمان عفونتهای مقاوم استفاده میشود)، مقاومت پدیدار شد.
یافتهها نشان میدهد پرمتیلنومایسین C لاکتون میتواند به عنوان گزینه امیدوارکنندهای برای مقابله با باکتریهای مقاوم به داروهای رایج باشد.
اوایل سال جاری، گروهی دیگر از محققان با همکاری تیم چالیس روشی اقتصادی برای تولید این آنتیبیوتیک به کمک مواد اولیه تجاری توسعه دادند. این دستاورد میتواند تولید انبوه این ترکیب را امکانپذیر سازد. بااینحال، محققان قصد دارند ابتدا بهطور دقیقتر مکانیزم عملکرد این مولکول در برابر باکتریها را بررسی کنند. همچنین مطالعات بیشتری برای بررسی سمیت این ترکیب در سلولهای پستانداران و امکان اصلاح آن برای کاهش اثرات جانبی در انسانها مورد نیاز است.
این پژوهش در ژورنال Journal of the American Chemical Society منتشر شده است.













